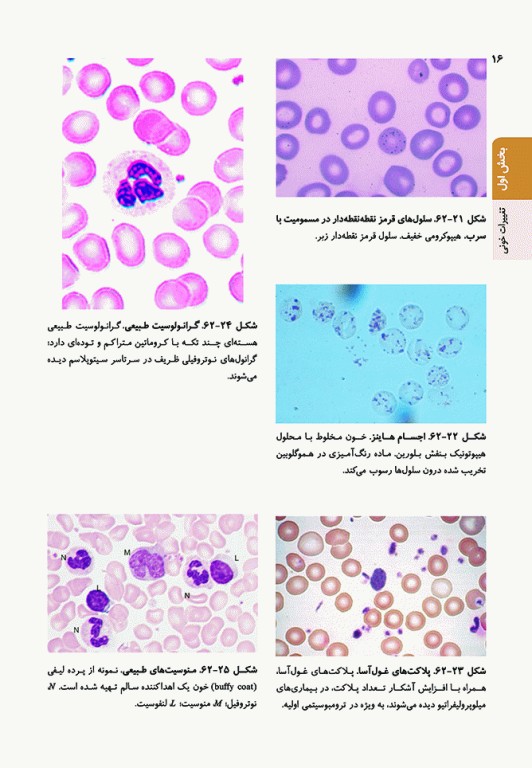
اصول طب داخلی هاریسون 2022 هماتولوژی

کتاب اصول طب داخلی هاریسون 2022 هماتولوژی ترجمه بخشی از "Harrisons Principles of Internal Medicine" است. ترجمه ویرایش بیست و یک مبحث هماتولوژی اکنون در اختیار دستیاران و دانشجویان پزشکی، پزشکان و مختصصان فارغ التحصیل قرار گرفته است. ترجمه این ویراست دو خصوصیت مهم دارد: یکی این که فصلهای الکترونیکی که در ویرایشهای قبلی ترجمه نشده است و دیگر اینکه این مهم را جناب آقای دکتر سامیک ملک، مترجم دقیق و چیره دست انجام داده اند و ترجمه بسیار دقیق، روان و قابل فهم صورت گرفته است و در نشر ارجمند به چاپ رسیده است.
- بخش اول-تغییرات خونی
- بخش دوم-اختلالات خونساز
- بخش سوم-اختلالات هموستاز